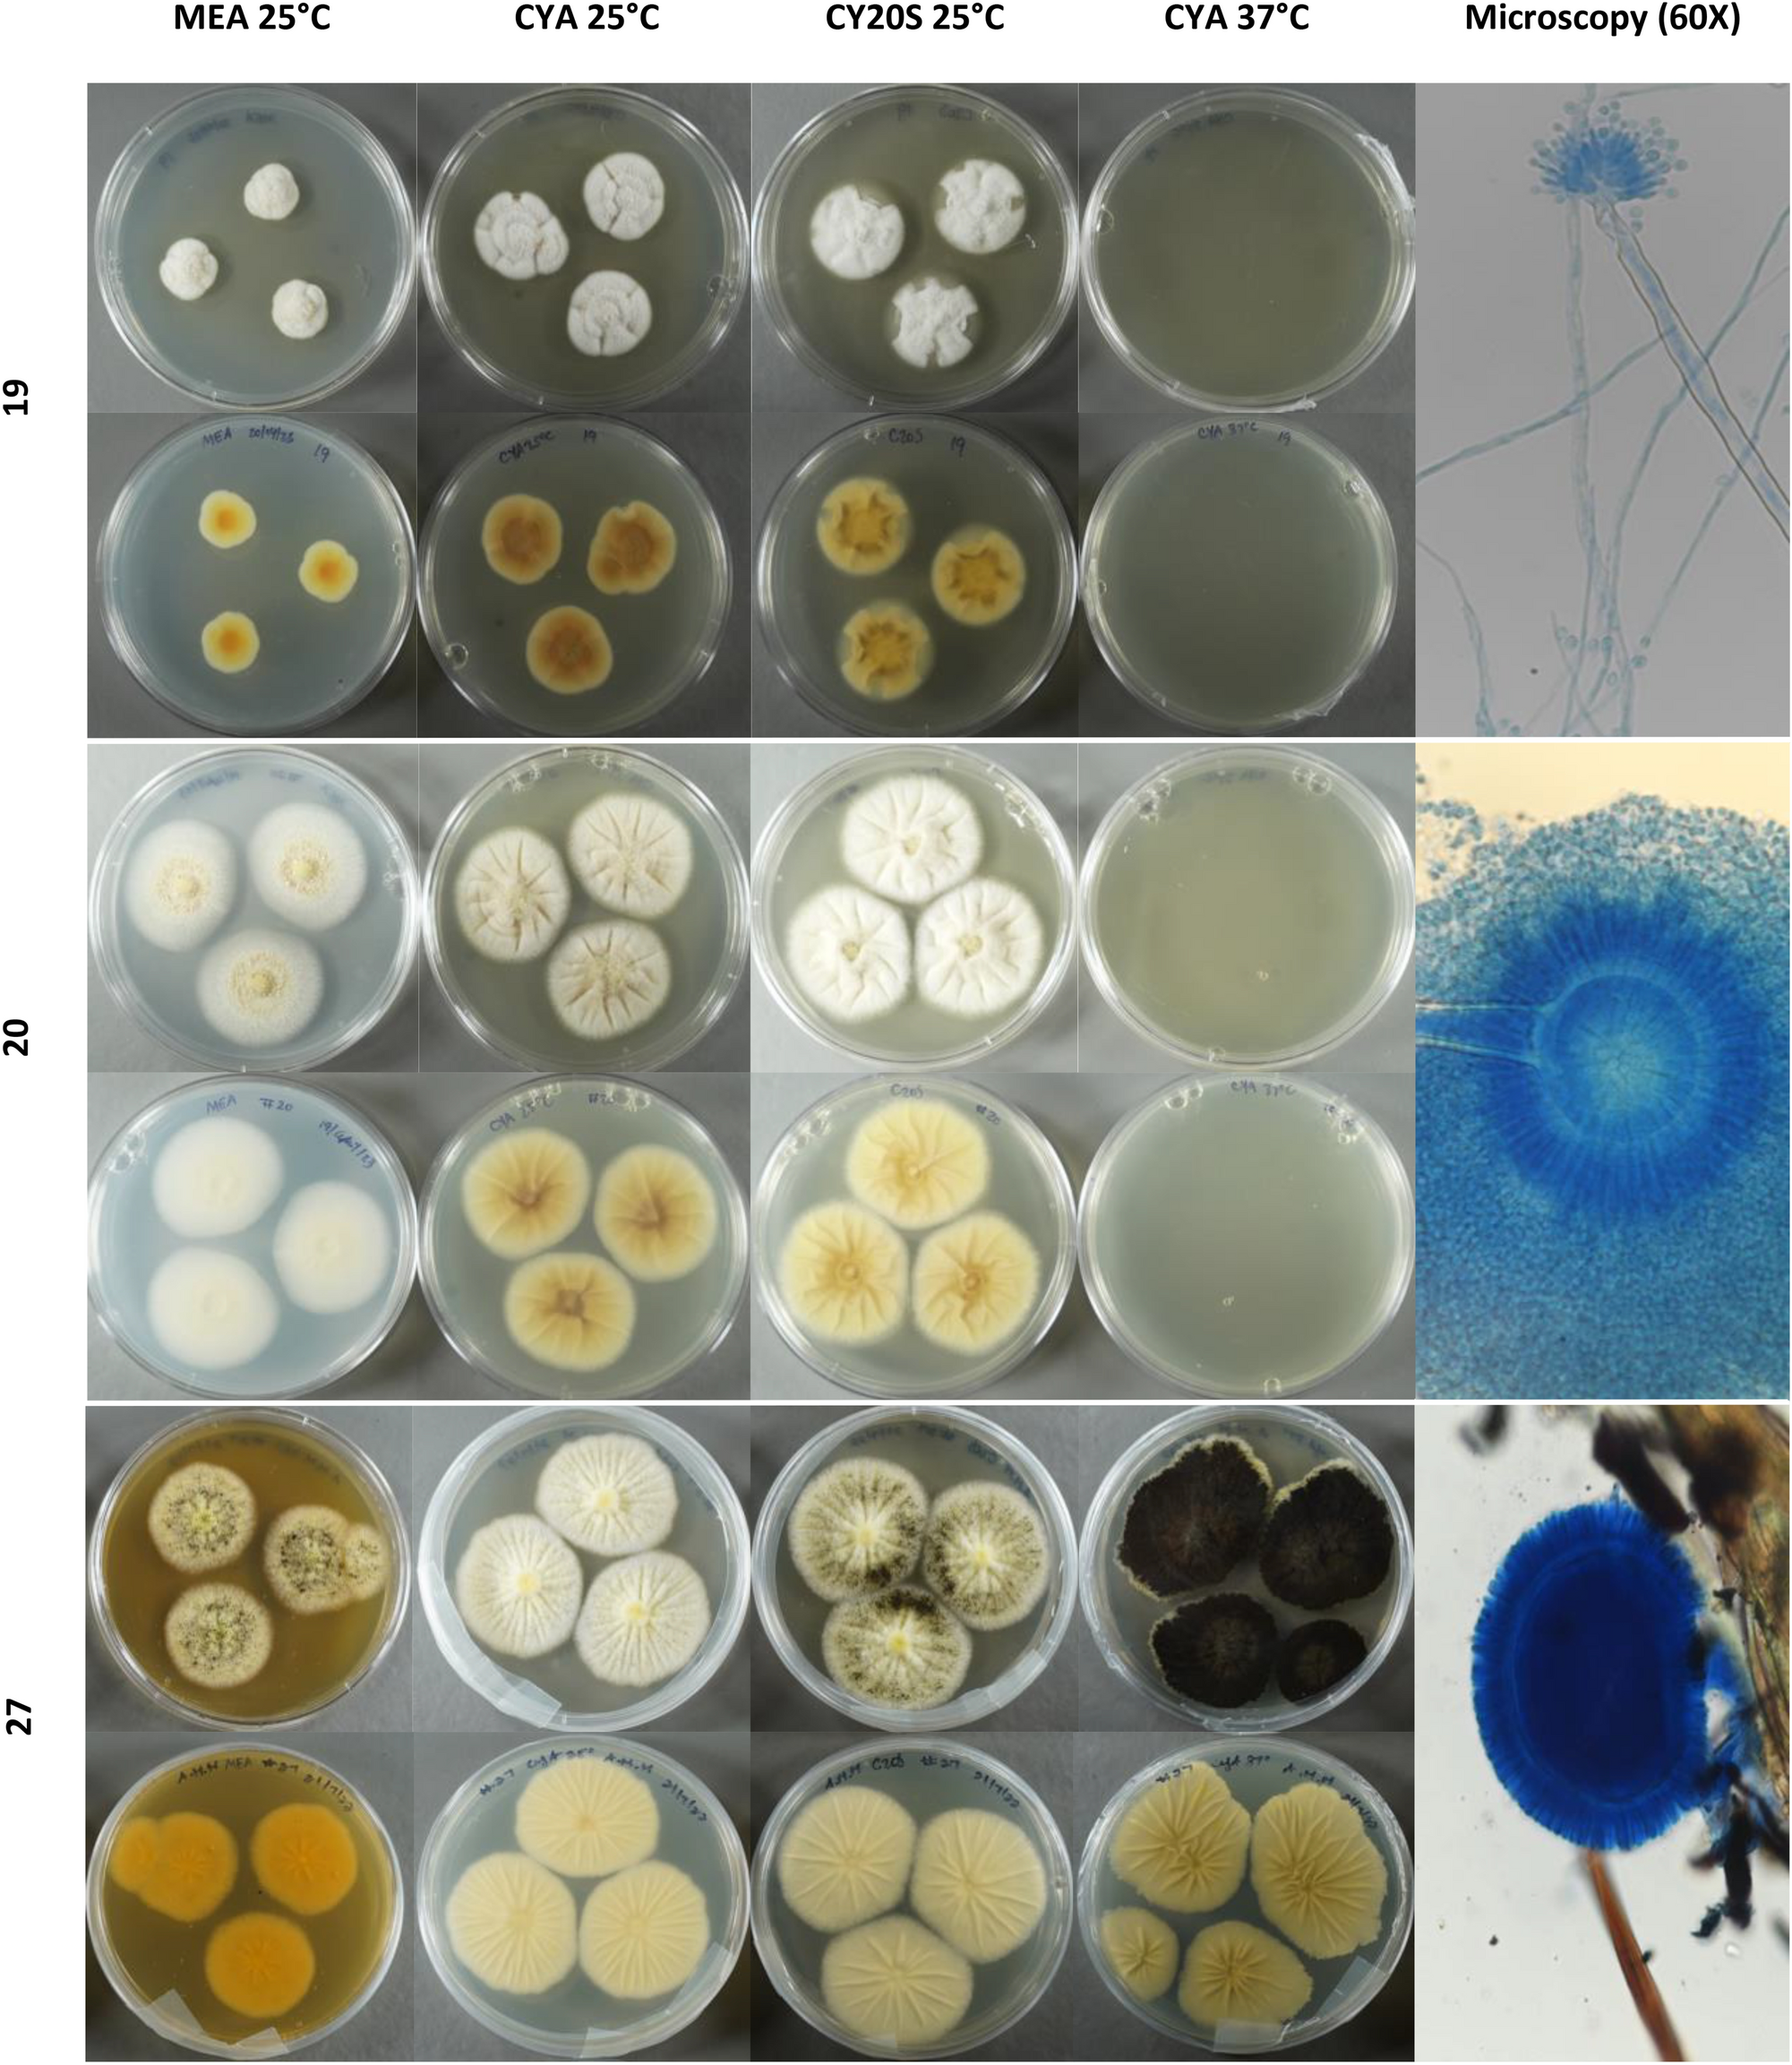
Fig. 1
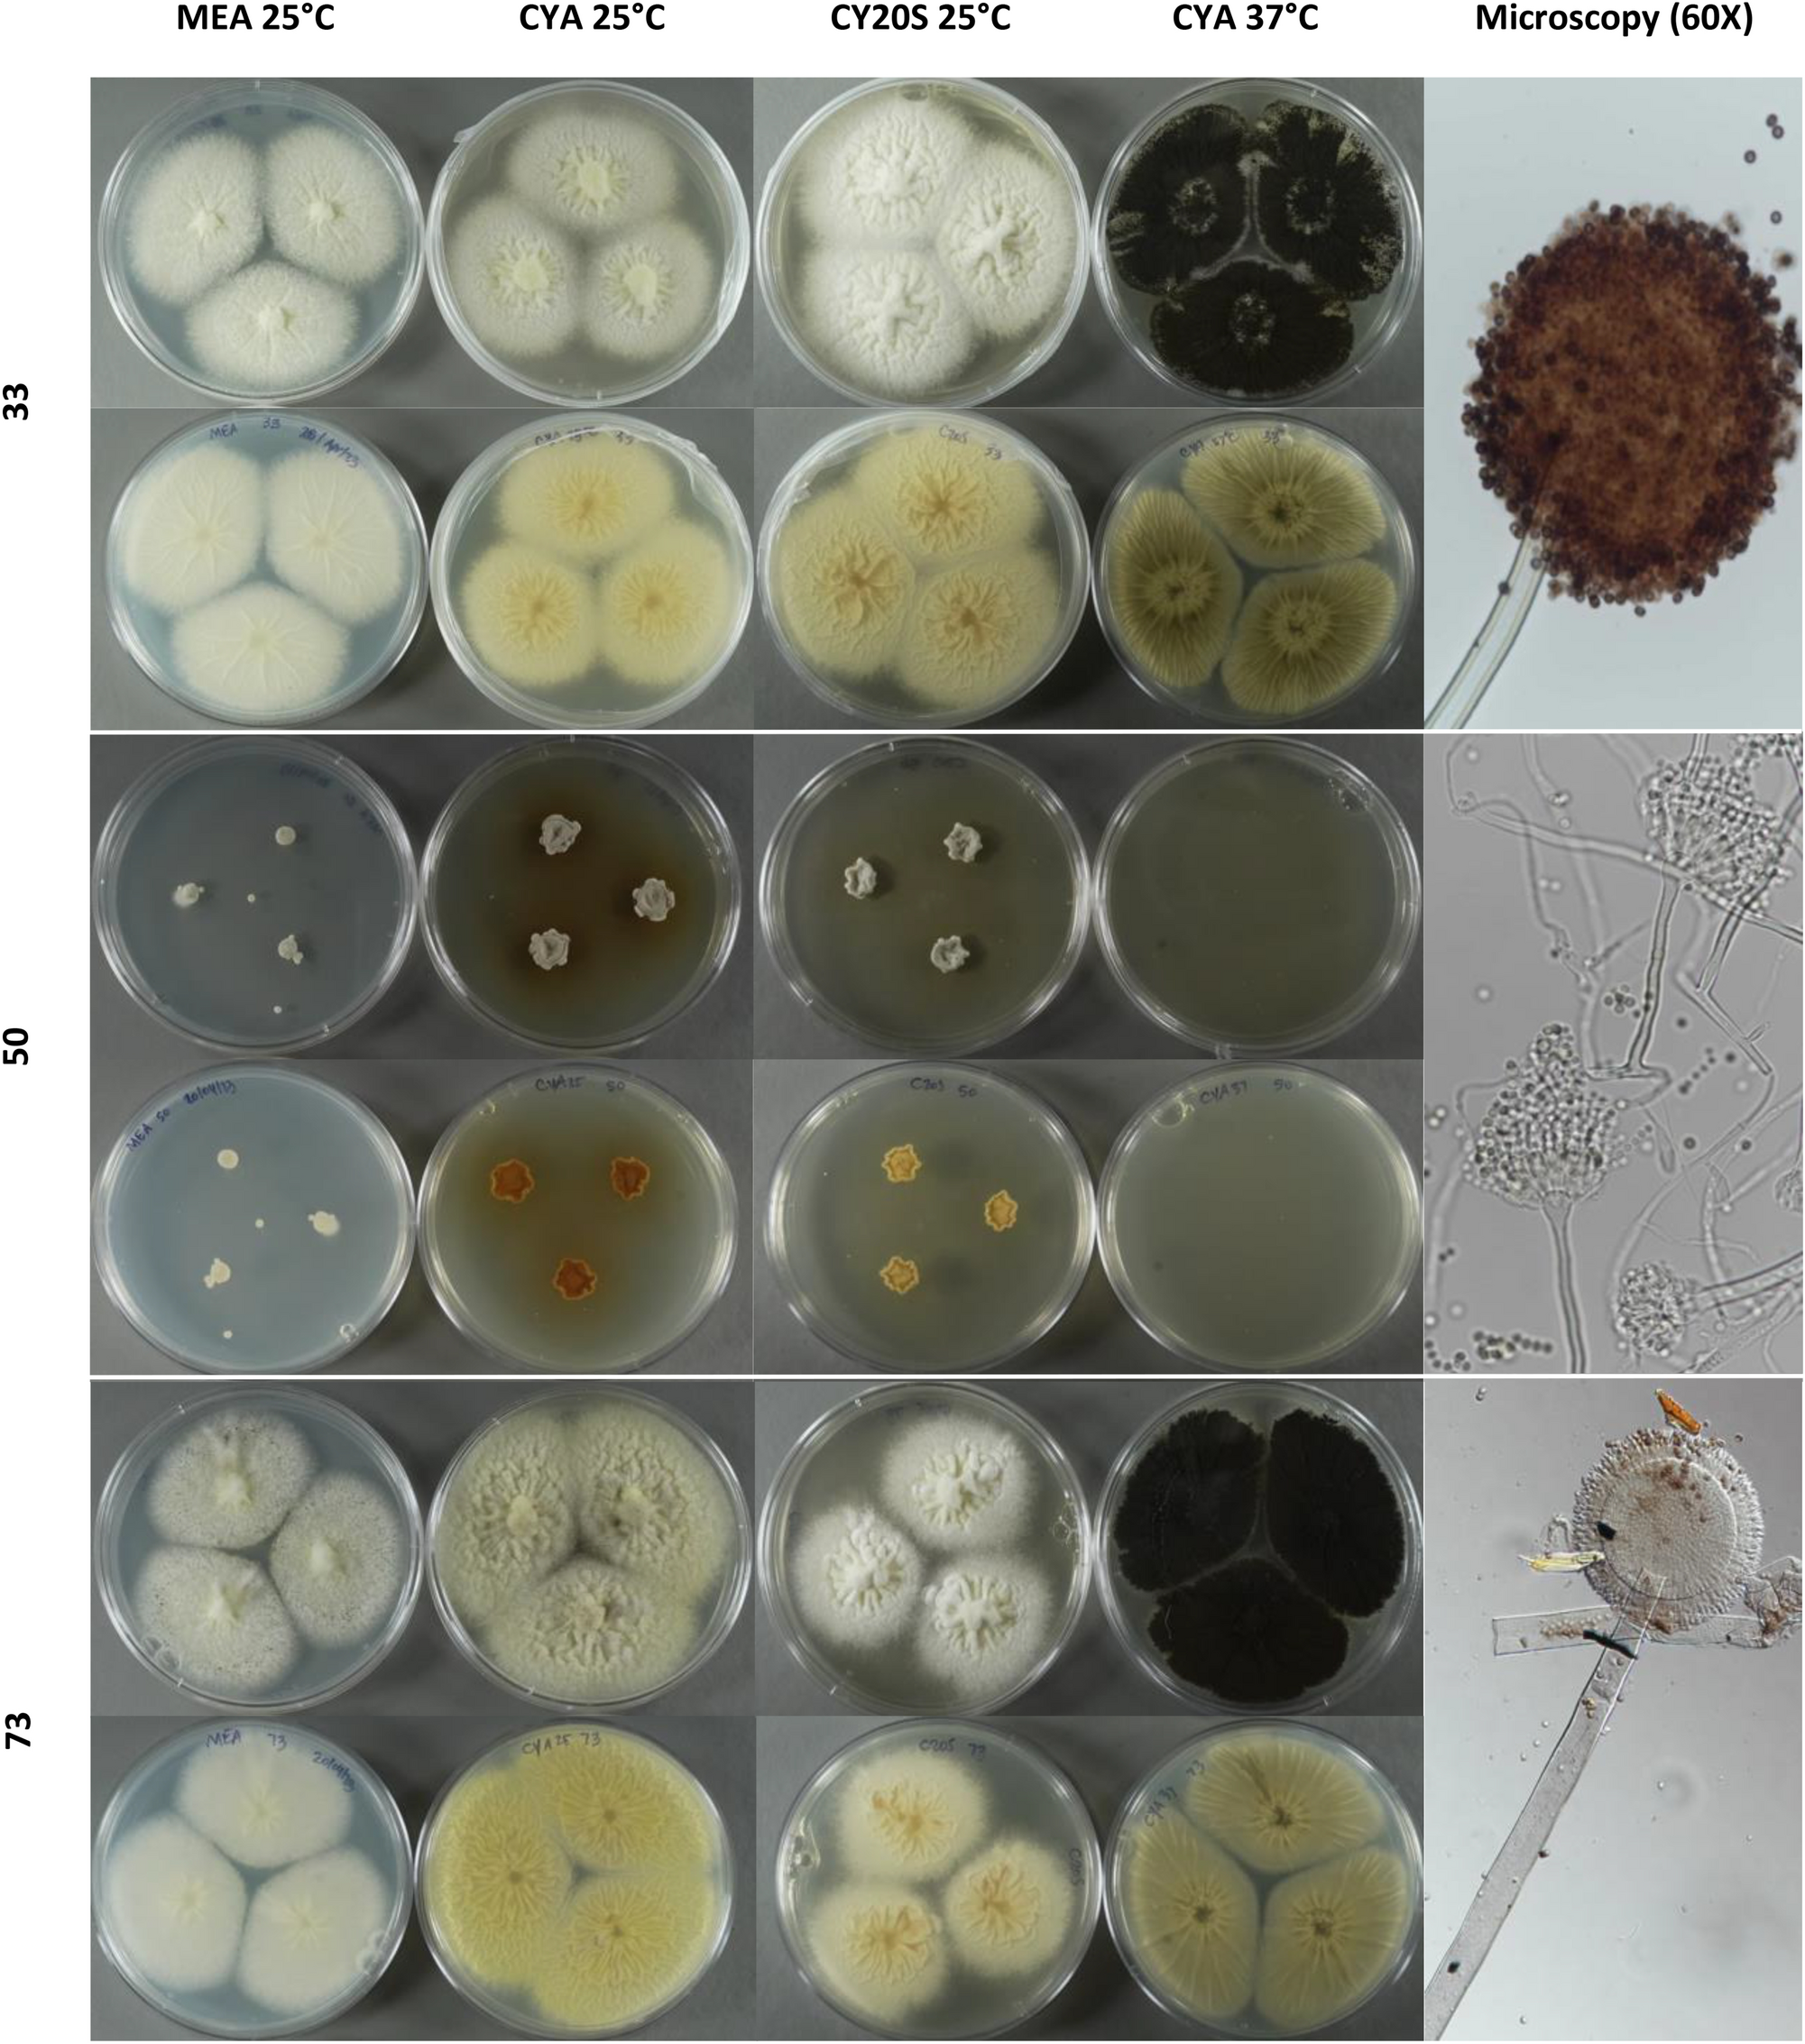
Fig. 1
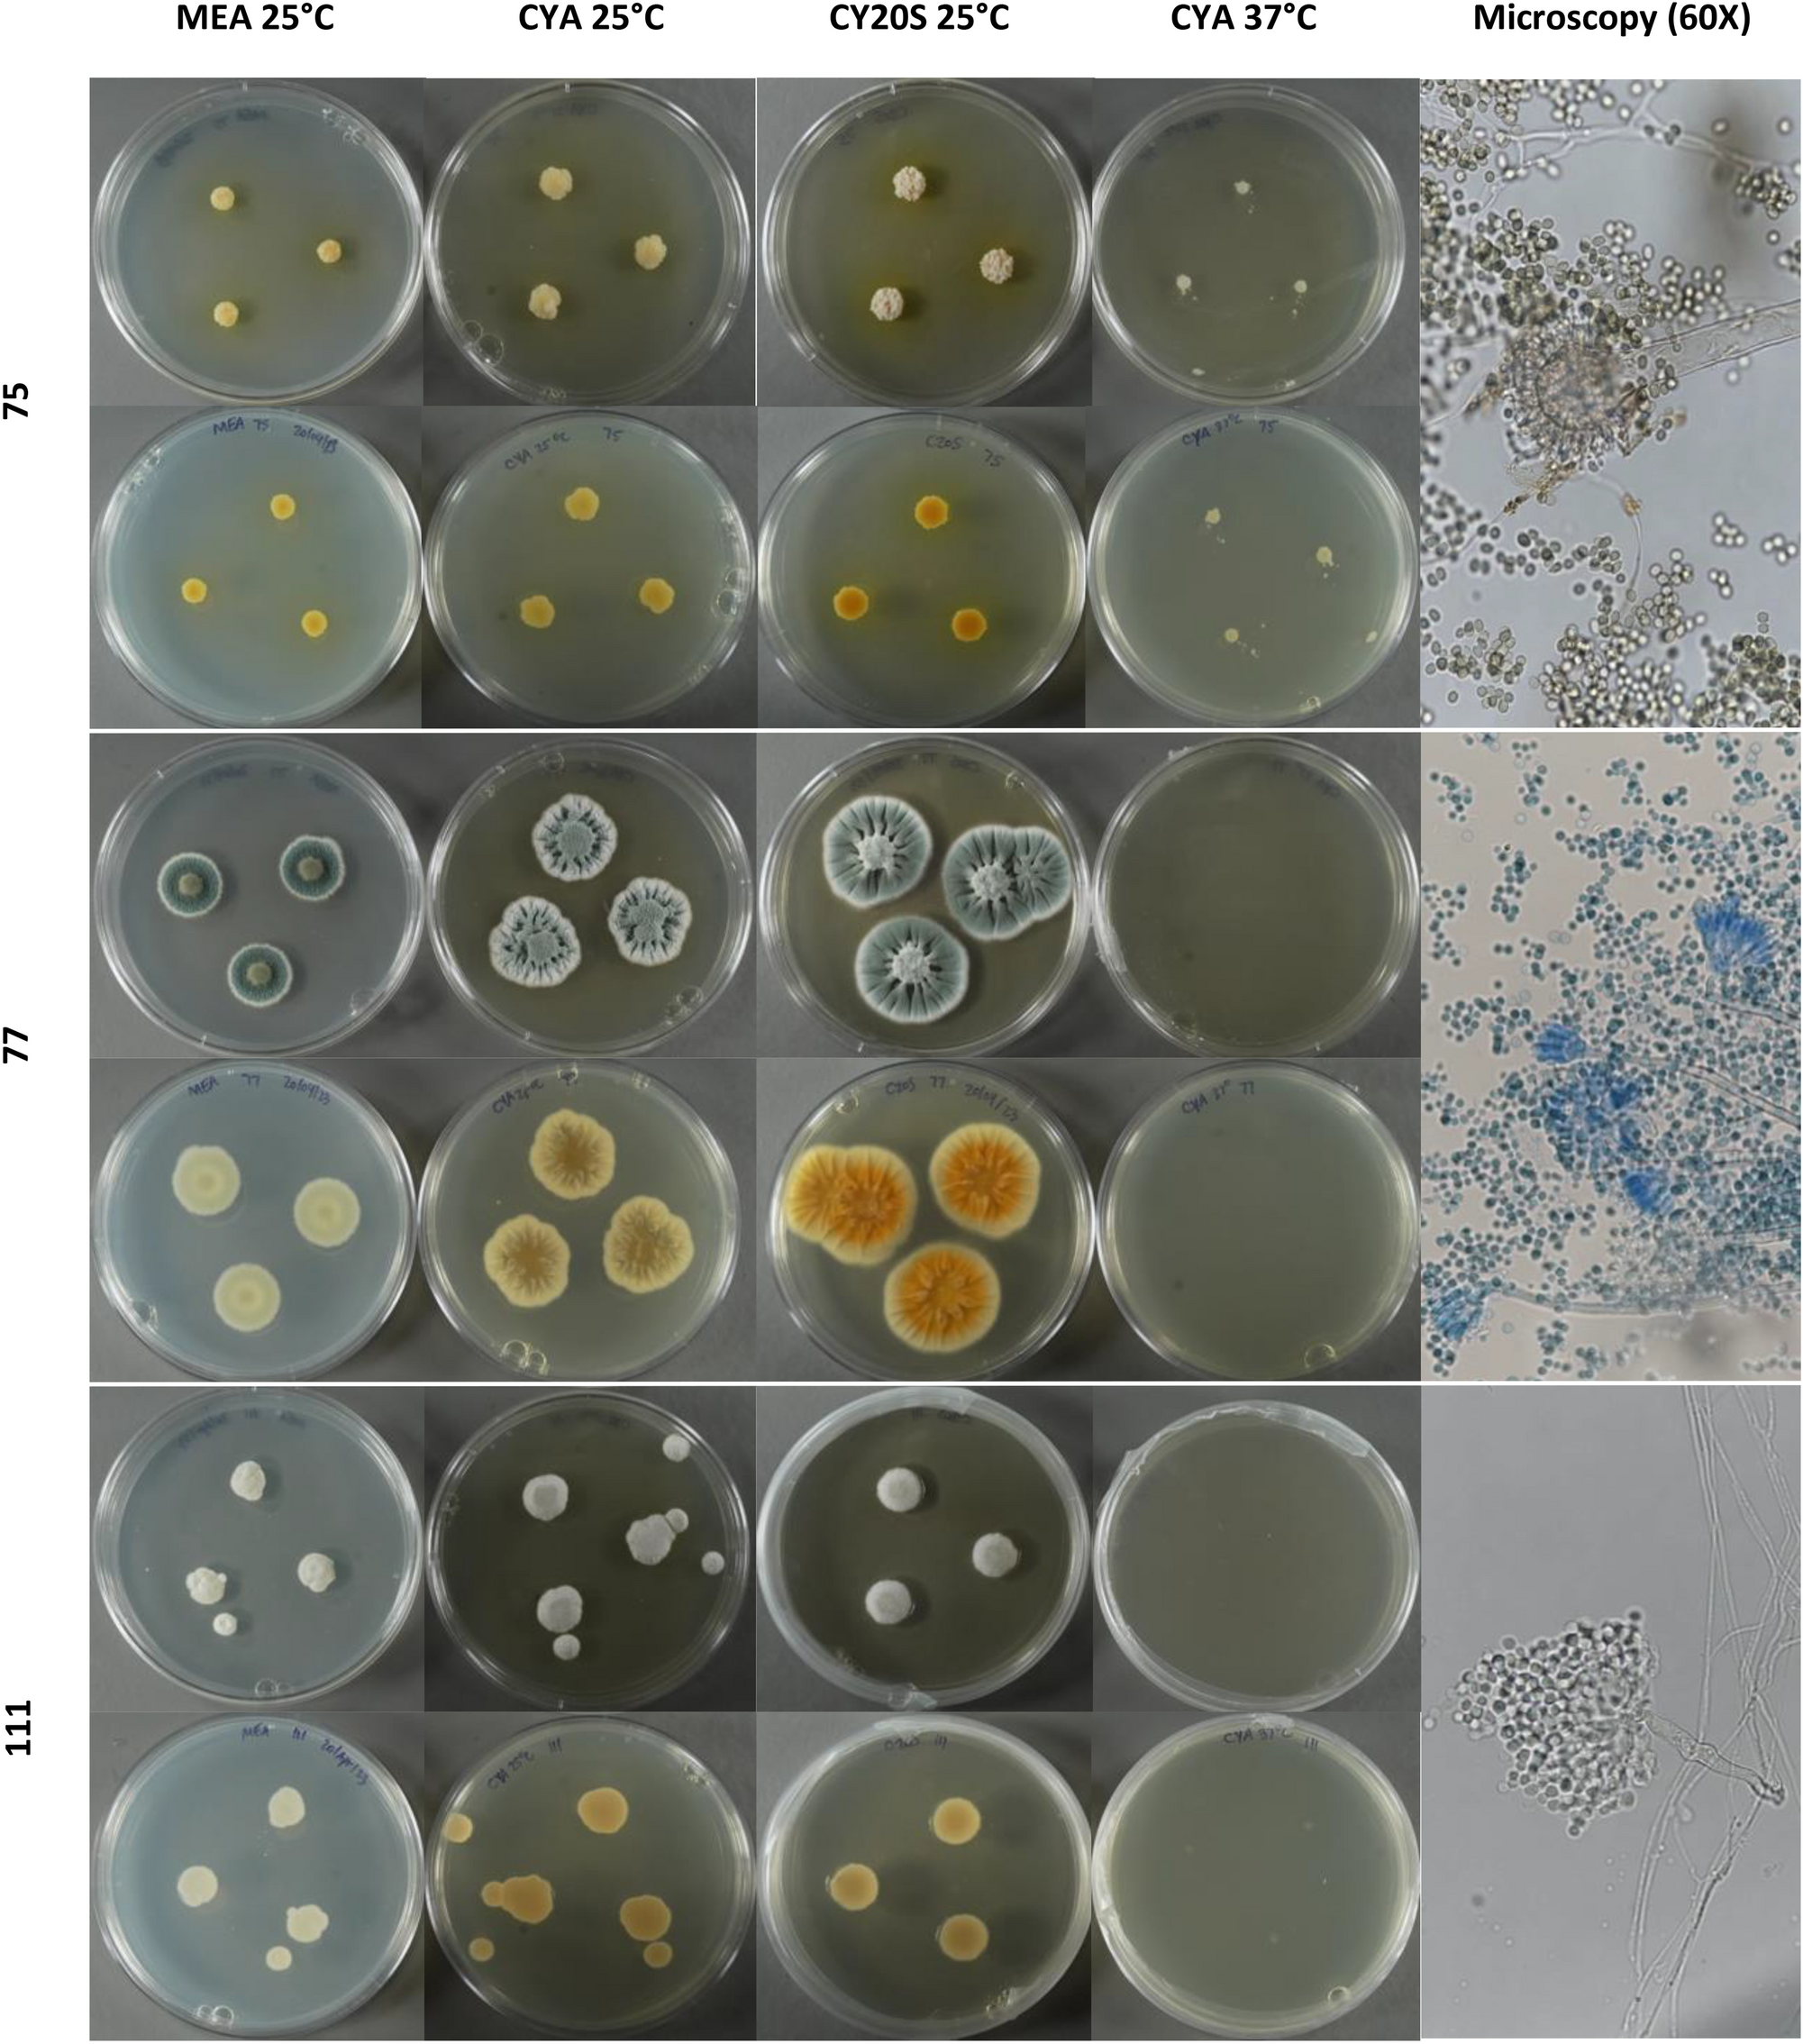
Fig. 1
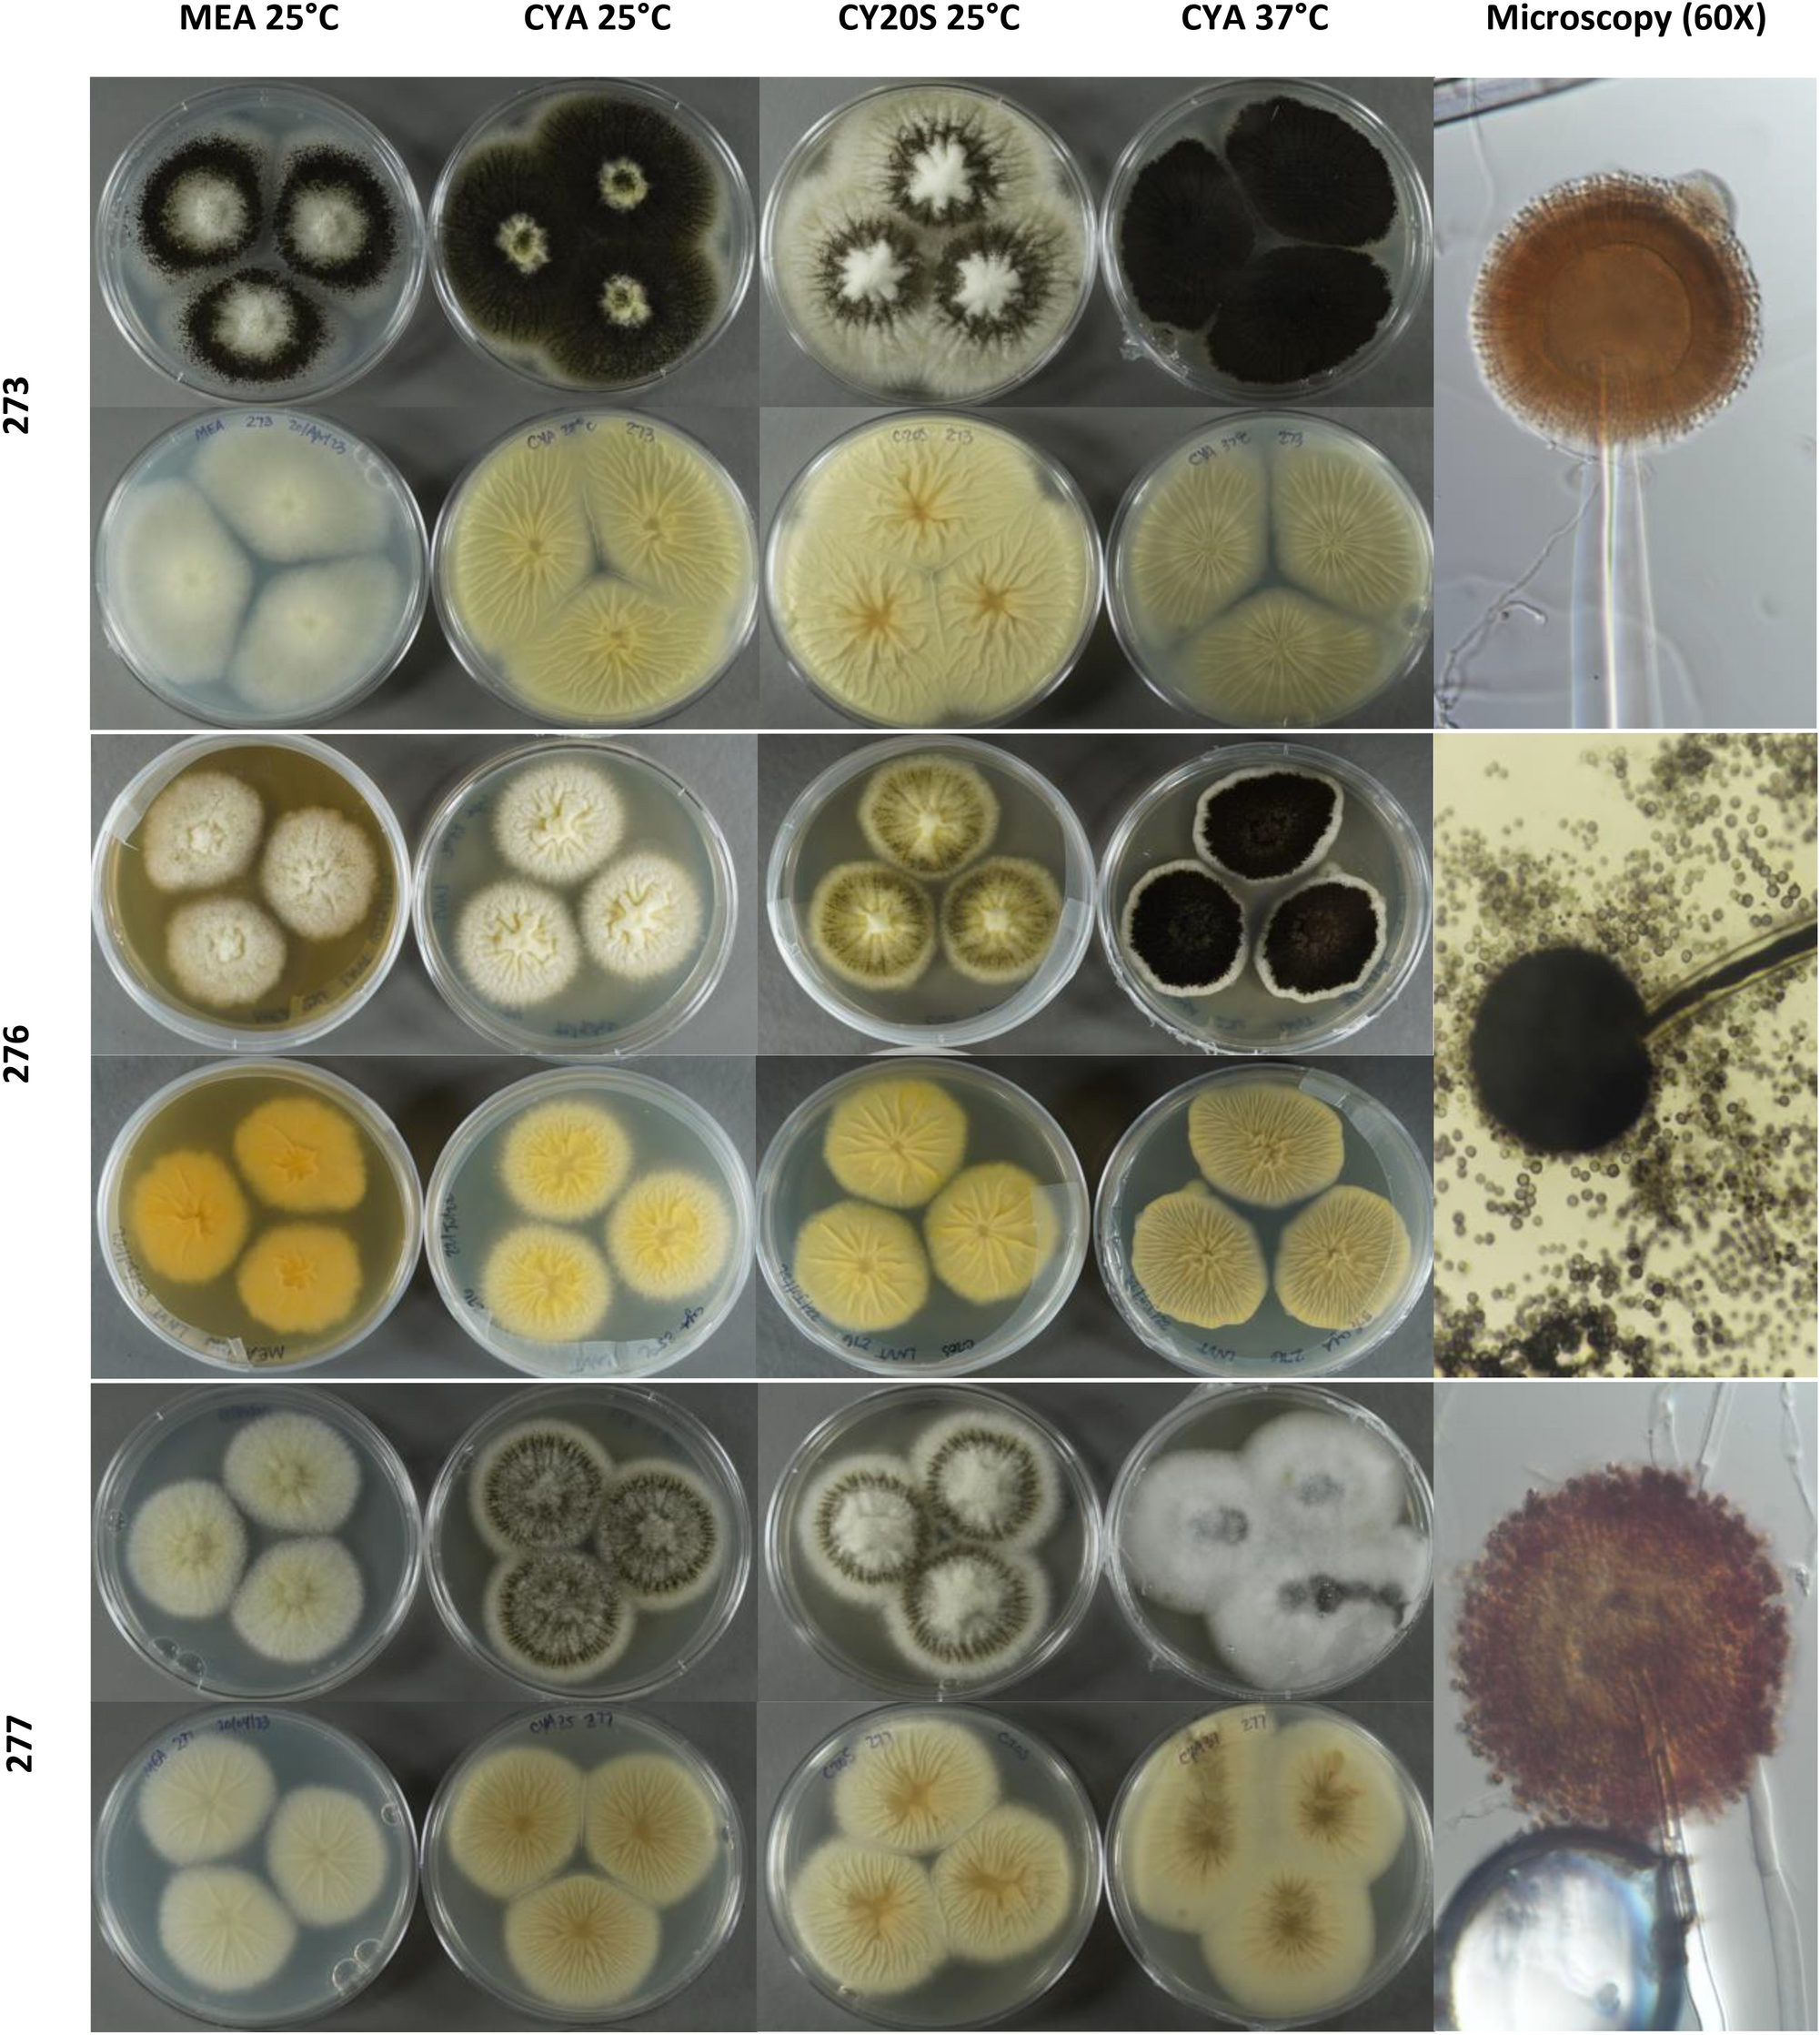
Fig. 1
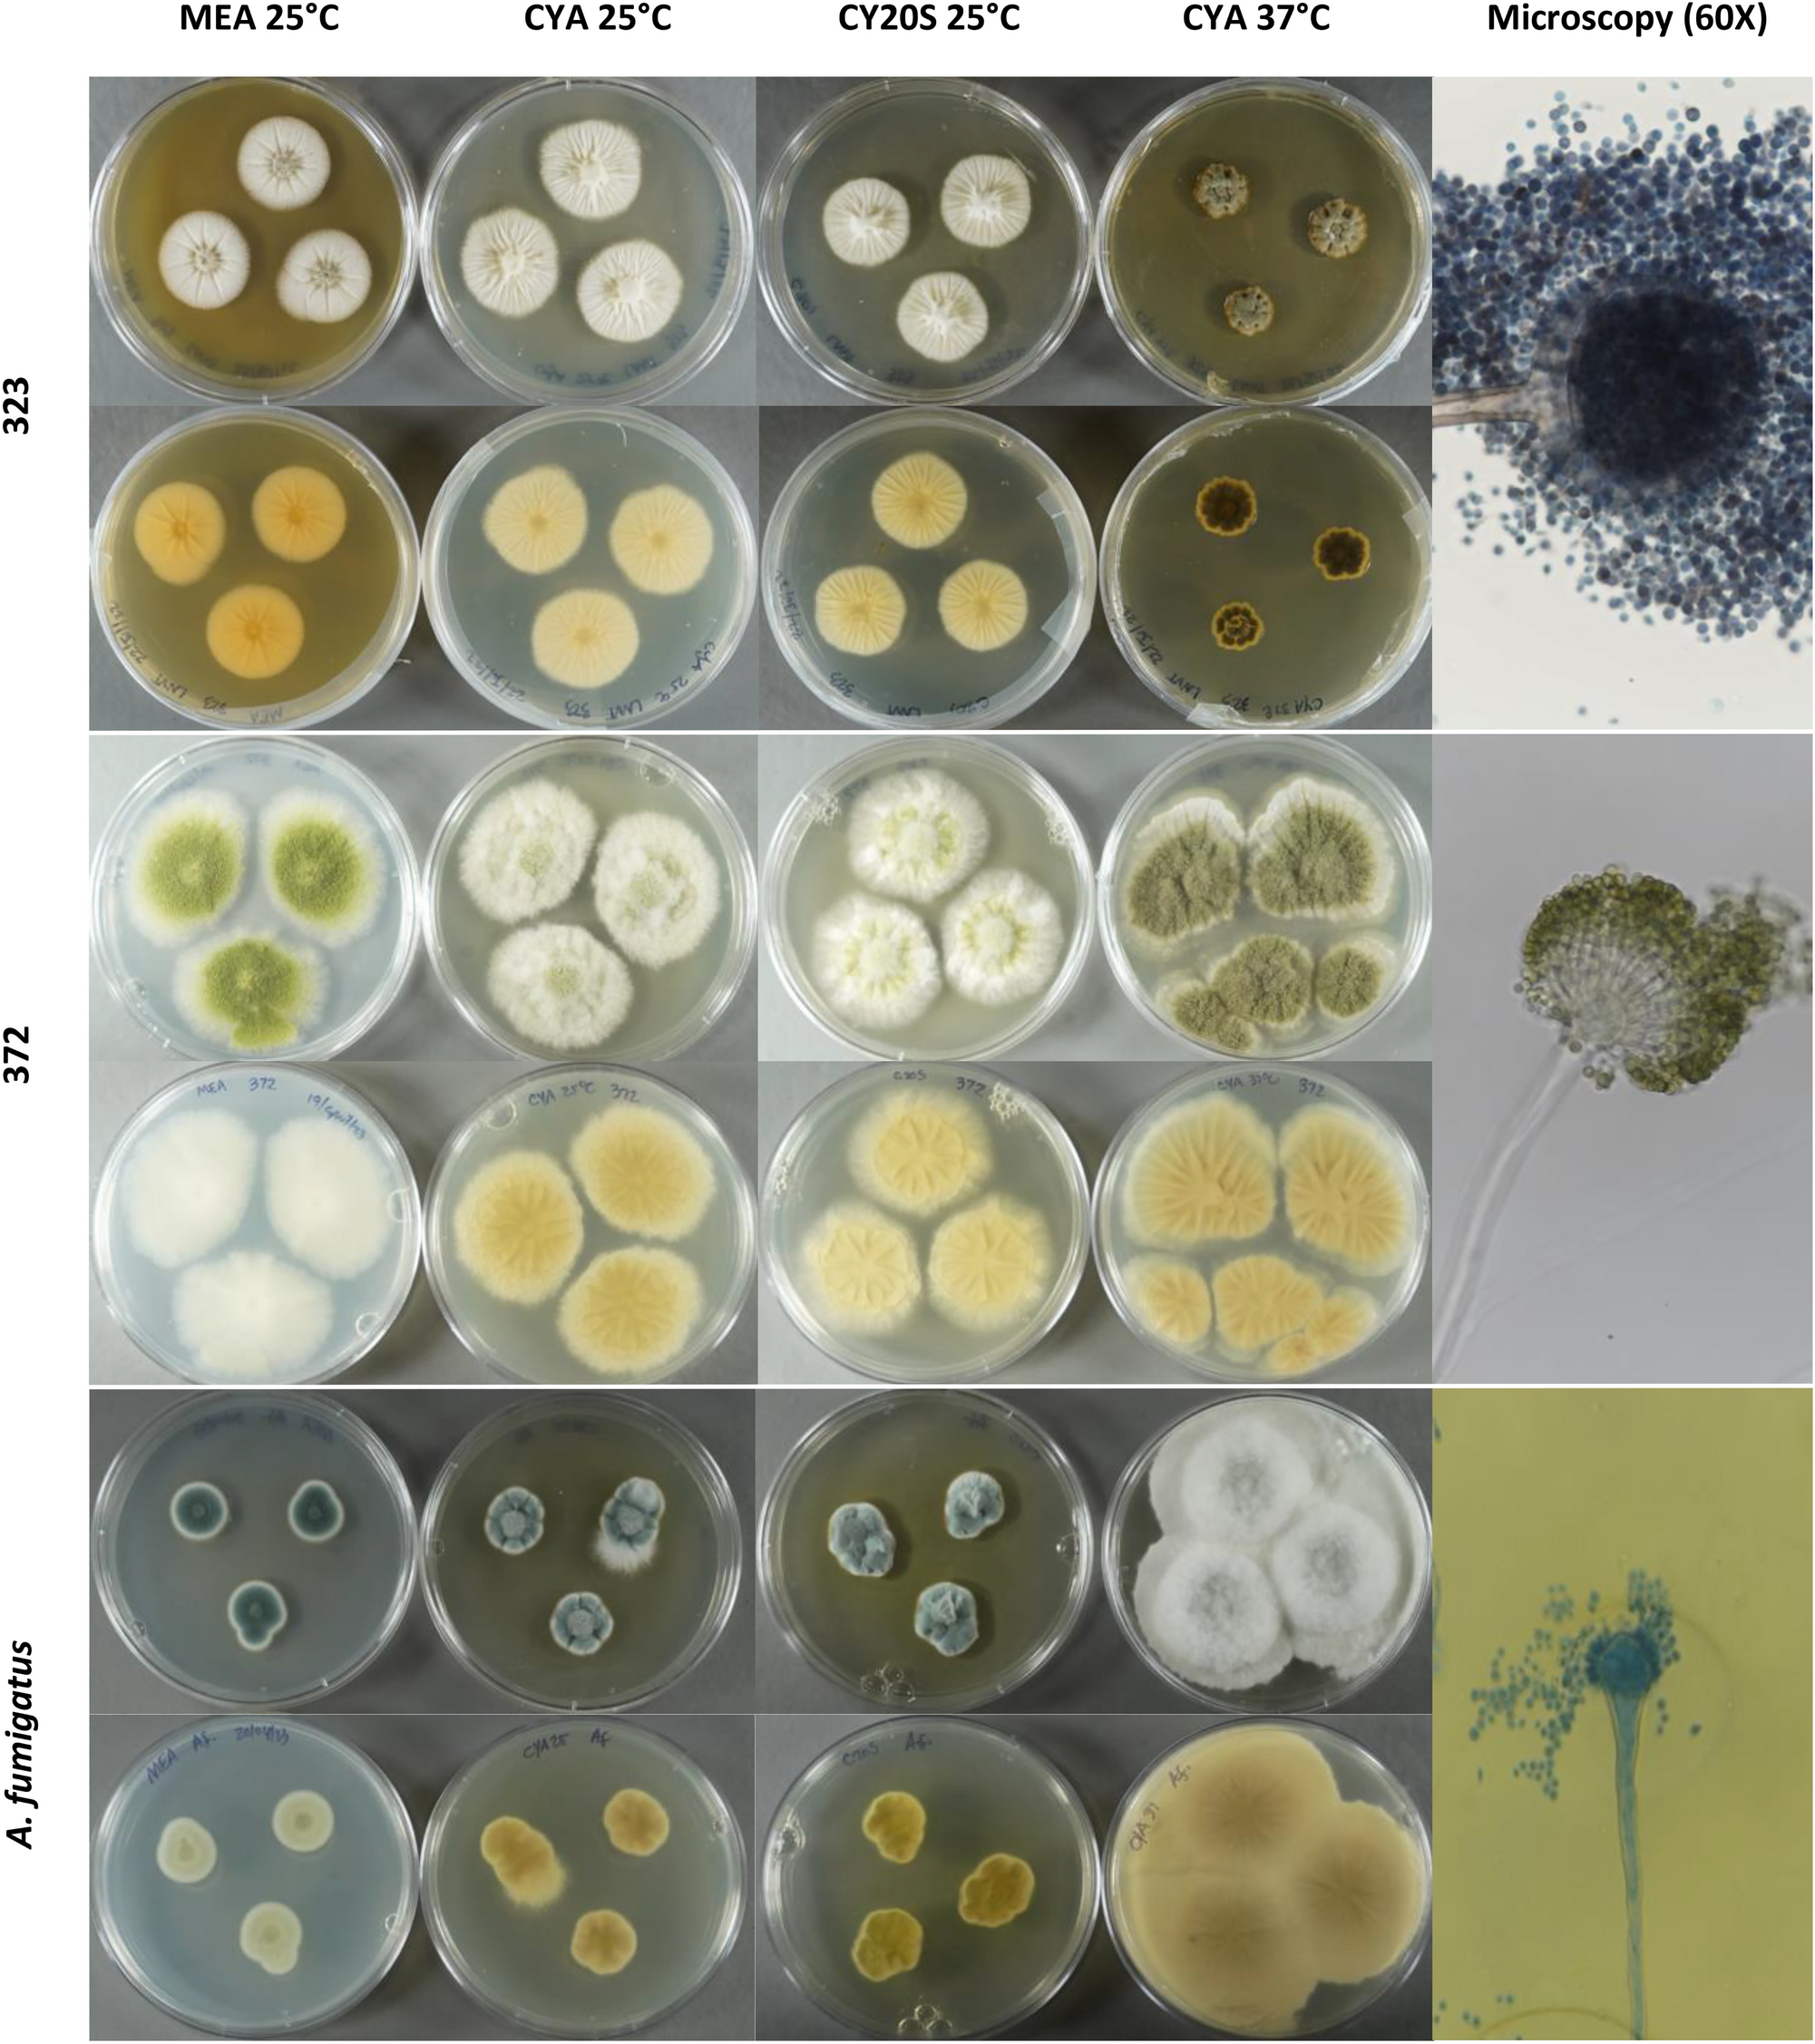
Fig. 1

Fig. 1










Macro and microscopic growth of Aspergillus isolates. Macroscopic growth comparison, from left to right, on MEA, CYA, CY20S (25 °C) and CYA (37 °C), after 7-day incubation. Microscopic photos from G25N microcultures on 60X.

Macro and microscopic growth of Aspergillus isolates. Macroscopic growth comparison, from left to right, on MEA, CYA, CY20S (25 °C) and CYA (37 °C), after 7-day incubation. Microscopic photos from G25N microcultures on 60X.